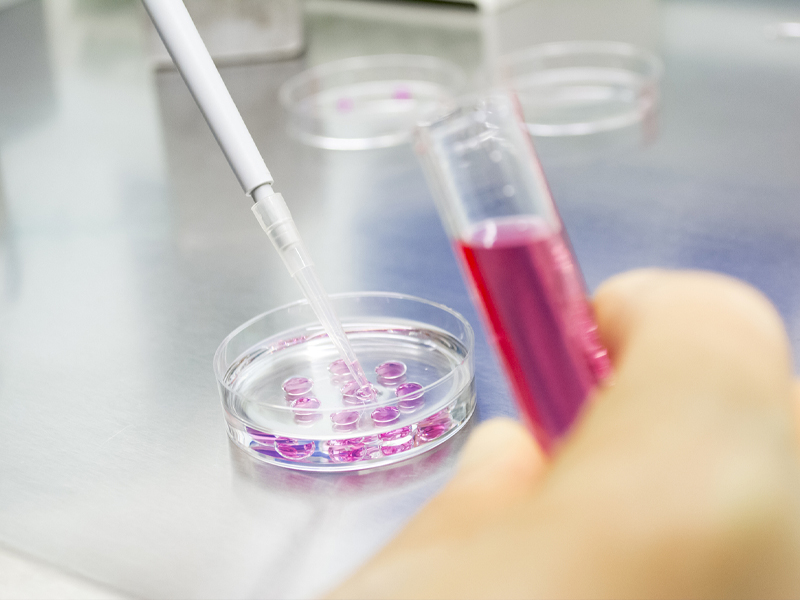
Cell culture (1)
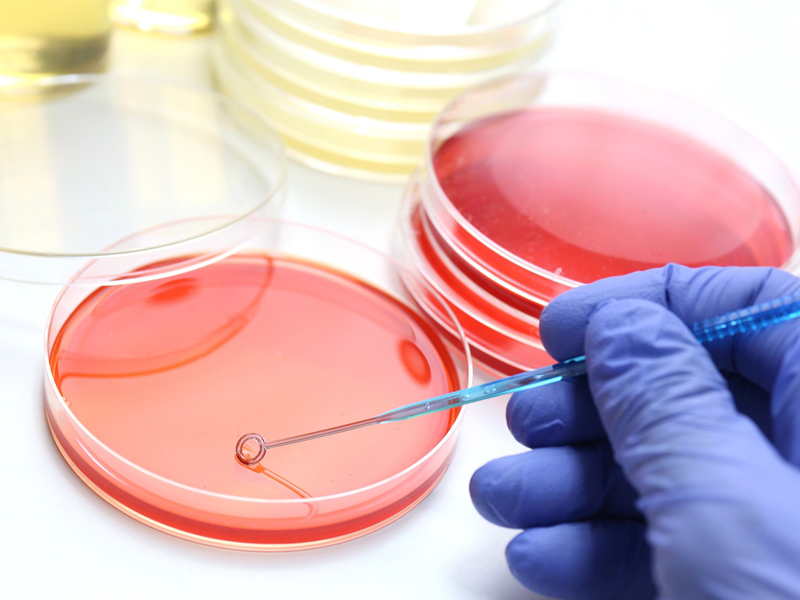
Cell culture (2)

In practical laboratory work, cell culture contamination is an issue almost every researcher encounters. At best, it affects cell condition and experimental data; at worst, it leads to the loss of entire batches of cells, increasing costs and significantly delaying research progress.
Therefore, understanding the sources of contamination and implementing preventive measures in advance are essential to ensuring successful experiments.
Why Is Cell Culture Prone to Contamination?
Cell culture essentially recreates an “ideal growth environment” in vitro. Culture media are rich in nutrients such as glucose, amino acids, vitamins, and serum, while incubators provide stable conditions including 37°C temperature, humidity, and controlled gas levels.
These conditions are not only ideal for cell growth but also highly favorable for microorganisms such as bacteria and fungi. Once contamination occurs, microorganisms can rapidly proliferate, compete for nutrients, alter the culture environment, and ultimately compromise cell viability or even cause cell death.
For this reason, aseptic technique is the most fundamental and critical principle in cell culture.
Common Types of Cell Culture Contamination
1. Bacterial Contamination (Most Common and Rapid)
Bacterial contamination is one of the most frequent issues in laboratories and can spread quickly.
Typical signs:
Cloudy culture medium
Yellowing of the medium
Numerous fast-moving particles under the microscope
Common causes:
Improper aseptic techniques
Contaminated consumables or containers
Contaminated media or serum
Once contamination occurs, it is usually recommended to discard the cells and thoroughly disinfect the equipment.

2. Fungal Contamination (Visibly Spreading)
Fungal contamination is less common but can spread rapidly once established.
Typical signs:
Flocculent or cotton-like floating particles
Visible hyphal structures under the microscope
Poor cell adhesion
Fungal spores are widely present in the air, and prolonged exposure during handling is a major risk factor.
3. Mycoplasma Contamination (Highly Concealed)
Mycoplasma contamination is often difficult to detect visually and is one of the most overlooked issues.
Possible indicators:
Slow cell growth
Abnormal morphology
Unstable or inconsistent experimental results
Regular mycoplasma testing is strongly recommended to ensure system reliability.

4. Cross-Contamination Between Cell Lines (Human Error)
In addition to microbial contamination, cross-contamination between different cell lines is also a critical concern.
Common causes:
Handling multiple cell lines simultaneously
Poor labeling and management
Shared pipettes or consumables
Such issues can directly compromise the reliability of experimental results.
How to Effectively Reduce Contamination Risk?
Prevention is far more important than post-contamination treatment. The following measures are recommended:
Perform critical operations in a biological safety cabinet
Strictly follow aseptic techniques
Minimize exposure time of culture vessels
Regularly clean incubators and laboratory environments
Establish standardized cell management and labeling systems
Avoid handling multiple cell lines simultaneously
Conduct routine mycoplasma testing
Implement proper cell freezing and recovery procedures
High-Quality Consumables Also Matter
In cell culture systems, the quality of consumables directly affects experimental stability.
Cell Culture Flasks / Plates
High transparency for easy observation
Stable surface treatment for adherent cell growth
Available in TC-treated and non-treated options for different applications
TC surface treatment enhances hydrophilicity of polystyrene, improving cell attachment efficiency.
Centrifuge Tubes / Cryovials
Reliable sealing performance
Suitable for cell collection, storage, and recovery
Serological Pipettes / Pipette Tips
Low retention design
Low adsorption performance
Helps reduce handling errors
Key Quality Standards for Cell Culture Consumables
Sterile
Endotoxin-free / Pyrogen-free
Non-cytotoxic
DNase/RNase-free, DNA-free
Conclusion
Cell contamination is not an occasional issue but one of the most common challenges in cell culture. By implementing standardized procedures, improving management systems, and using high-quality laboratory consumables, contamination risks can be significantly reduced, ensuring reliable and reproducible experimental results.
Follow on WeChat
Copyright @ 2024 Shanghai Welso Technology Co.,Ltd.